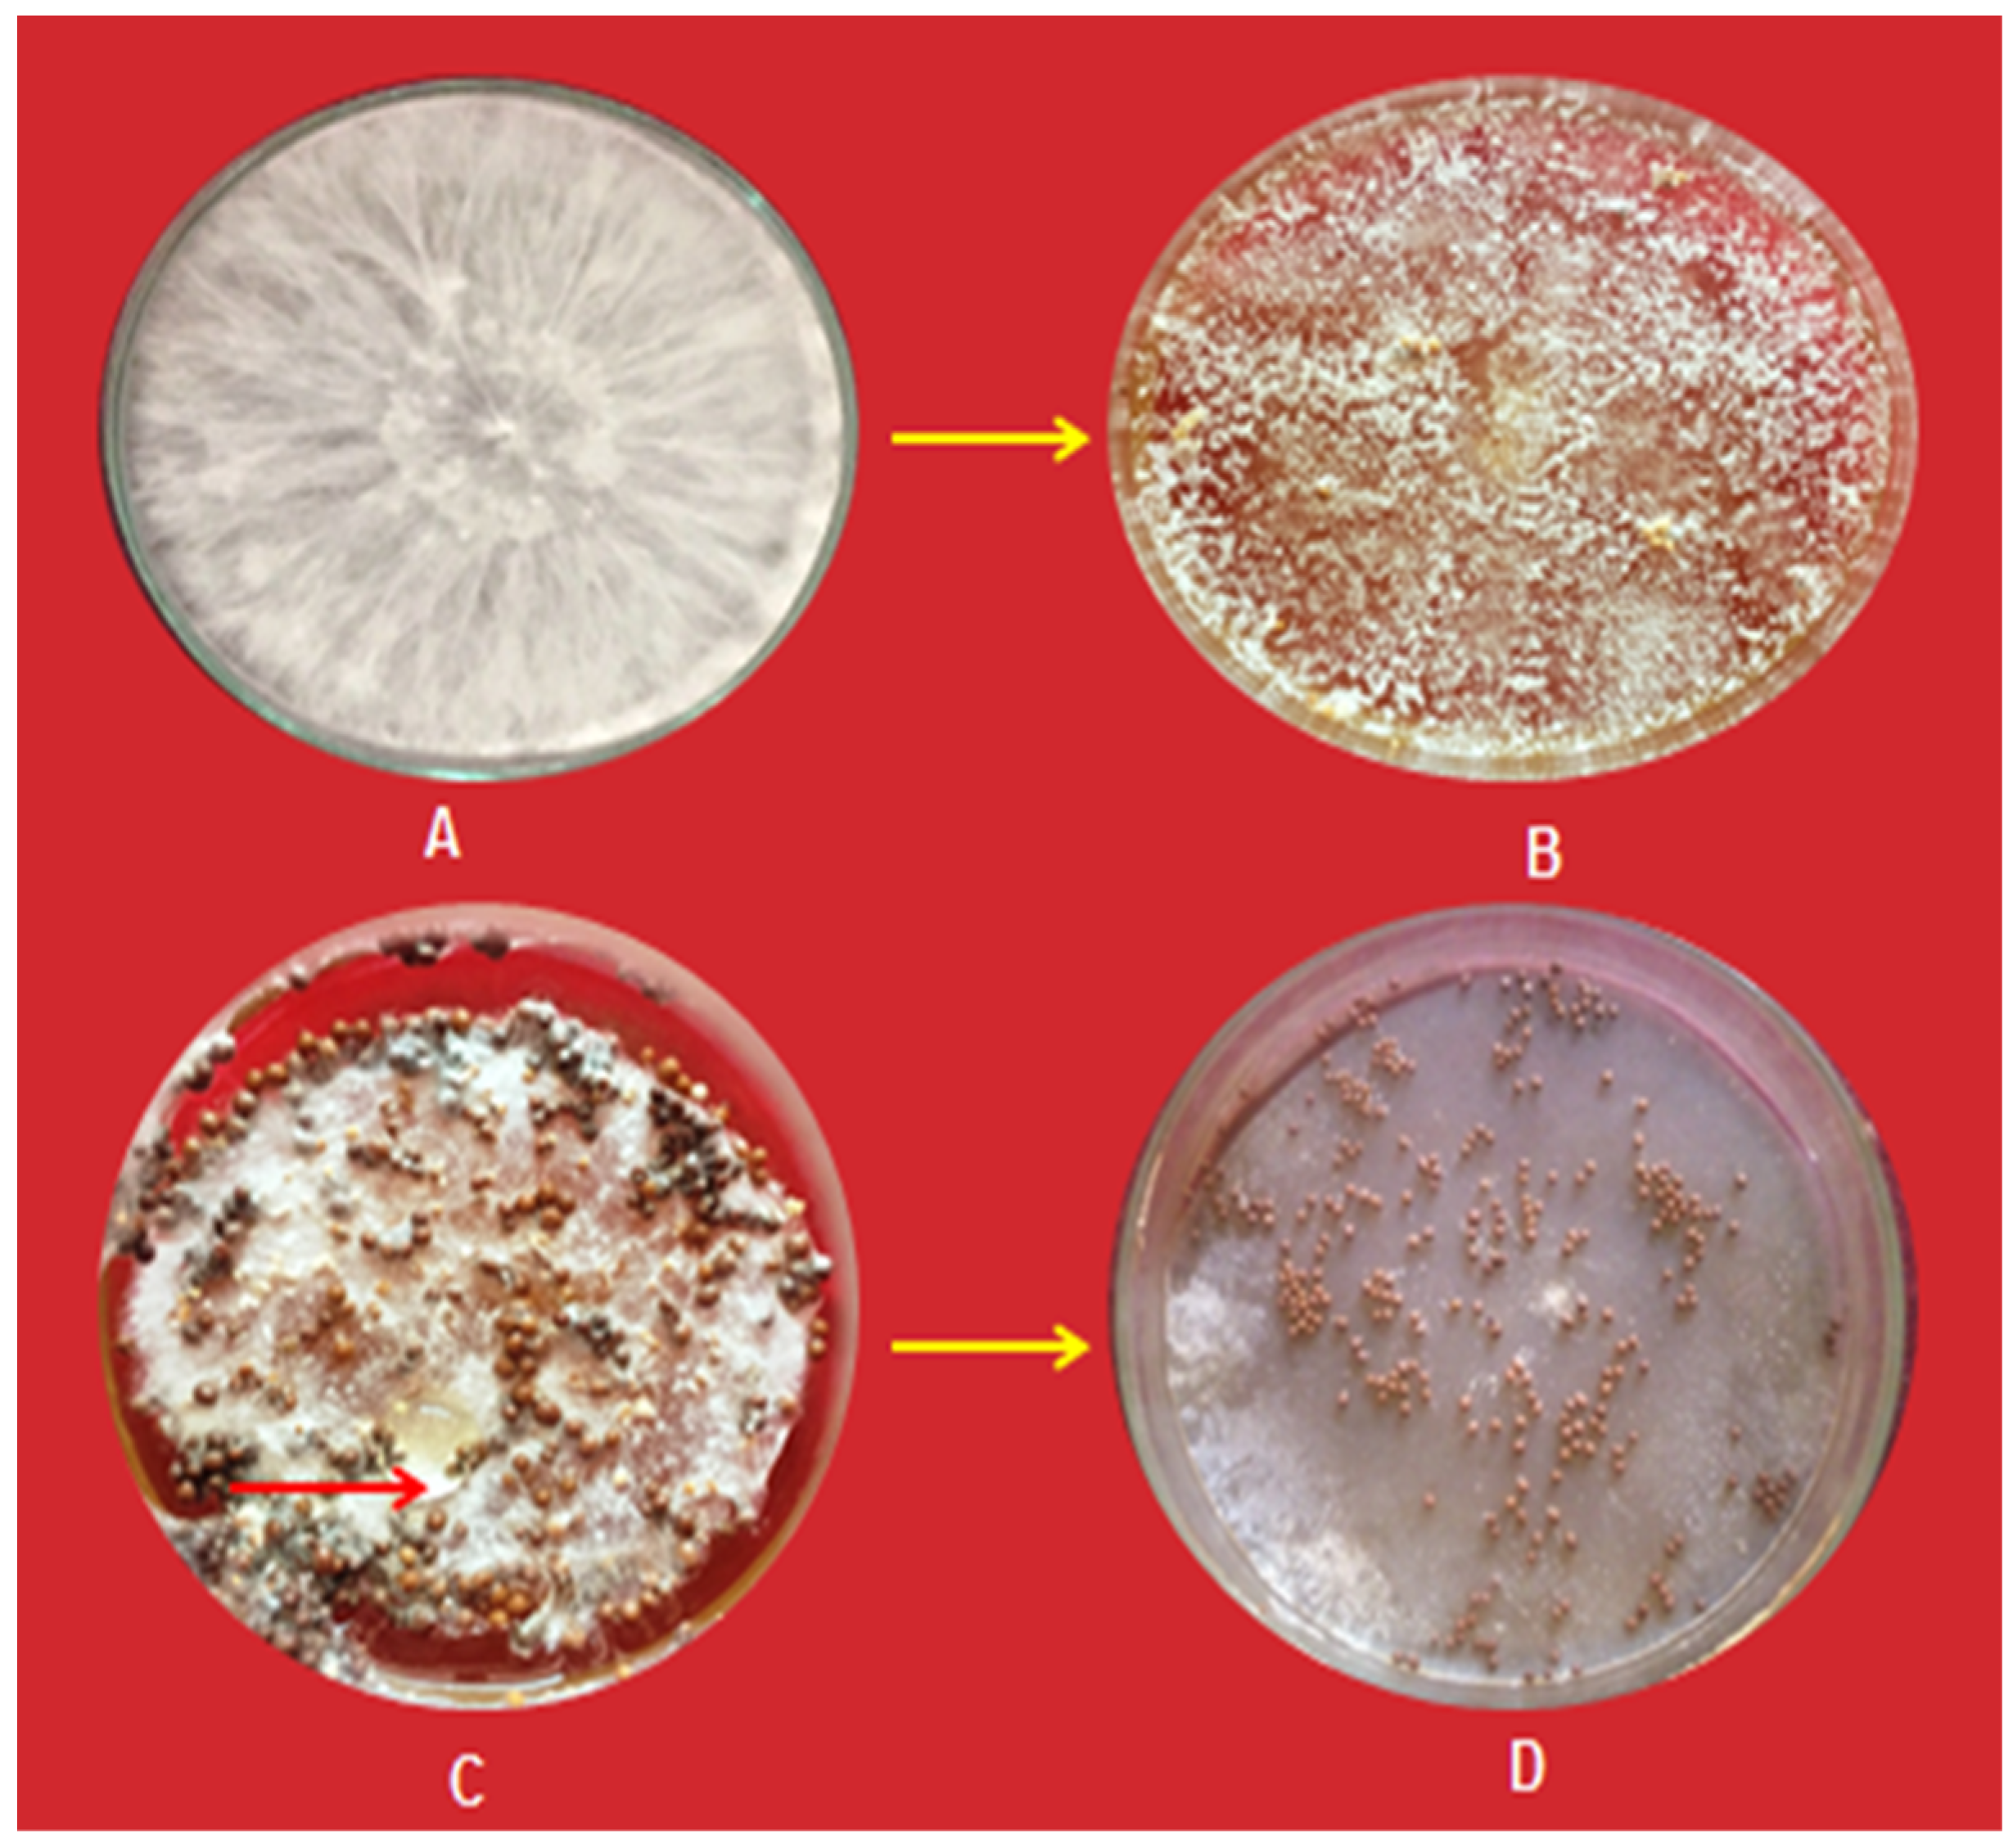
Pathogens 13 00632 g001

Abstract
Stem rot of groundnut (Arachis hypogaea L.) caused by Scelrotium rolfsii is the main threat to groundnut production, causing significant economic losses. The present study aims to provide an overview of the potentiality of Trichoderma viride (Tv), Trichoderma harzianum (Th), Pseudomonas fluorescens (Pf), and Bacillus subtilis (Bs), applied either individually or in mixed combination, against Sclerotium rolfsii (isolate SrBKN). The treatment with T. harzianum and P. fluorescens resulted in the highest mycelial growth inhibition (79.61, 83.51, and 86.77%), followed by T. viride and P. fluorescens (75.74, 79.63, and 83.14%). Under in vitro conditions, the combination of bio-agents at 5% culture filtrate proved to be superior against the test pathogen. Seed treatment and soil application of T. harzianum and Pf at 10 (5 + 5) g kg−1 + 10 (5 + 5) kg ha−1, followed by seed treatment and soil application of T. viride and Pf at 10 (5 + 5) g kg−1 + 10 (5 + 5) kg ha−1, resulted in the lowest disease incidence (7.40 and 8.0%), highest disease control (69.37 and 66.88%), maximum dry weight (151 and 147 g plant−1), highest increase in dry weight (75.58 and 70.93), highest pod yield (2665 and 2498 kg ha−1), and highest increase in pod yield (96.38 and 84.08%) under in vivo conditions. We present an effective bio-control-based management module from the lab to the field for the successful control of groundnut stem rot caused by S. rolfsii. Based on the results, it is concluded that the dual formulation of T. harzianum and P. fluorescens, followed by T. viride and P. fluorescens, were the most effective BCAs in suppressing the S. rolfsii. Therefore, an integrated disease management module with these BCAs needs to be developed and validated with a farmers’ participatory mode under field conditions.
1. Introduction
Groundnut (Arachis hypogaea L.), commonly called peanut, goober pea, pindad jack nut, and monkey nut, is a major oilseed crop cultivated in southern and northern India. It is also known as the king of oilseeds and was cultivated as early as 1000 B.C. [1]. India occupies the second position after China in terms of area and production of groundnut; it is chiefly cultivated in Gujarat, Rajasthan, A.P., Tamil Nadu, and Karnataka. It is grown in a 5.31 million ha area with an annual production of 7.57 million tons and productivity of 1424 kg ha−1 in India [2].
The groundnut crop is prone to various biotic stresses induced by bacterial, fungal, and viral diseases. Among fungal diseases, Sclerotium rolfsii is a deadly white mold that is soil-borne and has a wide host range [3]. Higher temperatures and moisture are favorable conditions for the development and survival of S. rolfsii. The incidence of S. rolfsii typically appears in one-month-old crops in which mycelium covers the stem near the soil surface, producing organic acids that are harmful to plants and cause cell necrosis. The primary diagnostic symptoms are mycelium formation and sclerotia on diseased tissue [4]. According to Akgul et al. 2011 [5], stem rot causes a 27% loss of groundnut crops in India, 10–50% in South America, and more than 25% in Australia [5]. The loss rate in severely infected fields can reach 80% [6,7]. Stem rot is most common during the kharif season, alone or in combination with other diseases, and it produces significant crop yield losses. This disease is the most devastating, ubiquitous, and yield-reducing factor in groundnut crops, particularly in Rajasthan’s northwestern plain zone [8].
Chemical pesticides play a crucial role in modern agricultural developments by reducing agricultural pests, and these chemicals are still growers’ first choice for effectively and rapidly controlling fungal diseases. However, frequent and indiscriminate use of these chemical pesticides causes various ecological disruptions, human health risks, a decrease in the population of beneficial microorganisms in the soil, ozone layer depletion, and the development of pesticide resistance [9,10]. Fungicides presently recommended to control this disease are protected for a limited period. Cultural methods (rouging, avoiding plant injury, and eradication of weed host) of stem rot management are not sufficiently effective due to the prolonged soil-borne nature of S. rolfsii. The most effective approach is to use resistant cultivars; however, availability and durability are important difficulties. In this context, biological controls are considered promising alternatives to fungicides and have opened up new vistas in stem rot management. Biological control agents (BCAs) have unique action mechanisms, including hyperparasitism, competition, antibiosis, and induced systemic resistance [11]. Studies conducted by Elad et al. (1983), Rekha et al. (2012), Safari Motlagh et al. (2022), and F. Sultana and M. M. Hossain (2022) have shown the efficacy of biological control agents against Rhizoctonia, Pythium, Fusarium, Verticillium, and Sclerotium rolfsii under in vitro and in vivo conditions [12,13,14,15]. The need for bio-agents in India and the world is continuously increasing due to the adverse effects of chemical pesticides on the environment [16,17]. When BCA-based formulation is used for stem rot management, its efficacy can be equal to or better than traditional fungicides in groundnut crops due to chemical compatibility [18]. The combination of bio-agents and lower doses of fungicides has been utilized to combat various soil-borne diseases [19].
The primary goals of this study are to develop a dual microbial consortium and to investigate the potential of antagonistic BCAs in terms of efficiency and efficacy in reducing mycelial growth and disease incidence of stem rot under field conditions, as well as their effects on dry weight and pod yield of groundnut plants.
2. Materials and Methods
2.1. Isolation and Identification of Causal Pathogen
Stem rot-infected groundnut plants showing symptoms of disease and sclerotia were collected from the Bikaner (isolate SrBKN), Jaipur (isolate SrJPP, Churu (isolate SrC), and Sikar (isolate SrS) districts of Rajasthan, India. Infected samples were gently washed in tap water and subsequently with sterile water and cut into small pieces, then sterilized with one percent NaOCl solution for 1 min. After three washings, diseased stem pieces were aseptically transferred into streptomycin sulfate (0.003%/L) mixed potato dextrose agar (PDA) media contained in Petri dishes. Then, plates were incubated in BOD for seven days at 26 ± 2 °C for the growth of the pathogen. The mycelium developed from diseased tissues was sub-cultured aseptically into PDA tubes and Petri plates. The local isolate SrBKN of Sclerotium rolfsii was used in this study, which was purified by the hyphal tip technique [20]. S. rolfsii was identified based on morphological and cultural attributes of mycelium growth appearance and sclerotia. The morphological characters, viz. sclerotium formation, their color, shape, size, and mycelium growth were recognized under low power magnification (10×) microscope and identified as per key points described in “Illustrated Genera of Imperfect Fungi” [21], Figure 1 and Figure 2. The isolate SrBKN of S. rolfsii was selected from our previous published work after confirmation by both morphological and molecular basis using ITS primers [22].
Figure 1.
Different sclerotium stages of Sclerotium rolfsii. (A) White fluffy growth of mycelium; (B) Young sclerotia; (C) Gummy material around sclerotia; (D) Mature sclerotia.
Figure 2.
Identification of Sclerotium rolfsii on the basis of morphological features.
2.2. Pathogenicity Assay and Validation of Koch’s Postulate
The pathogenicity test of S. rolfsii causing stem rot disease in groundnuts was confirmed in earthen pots by the stem inoculation technique described by [23]. Sterilized earthen pots (24 cm diameters) were filled with autoclaved, sterilized soil, then seeds of groundnut (HNG-10) were surface sterilized with 5% (v/v) sodium hypochlorite for 5 min followed by three washings with water and then sown in the earthen pots. After germination, 4–5 seedlings were maintained in each pot for inoculations of the test pathogen. For inoculum, sand maize meal medium was prepared in 2:1 proportion, suitably moistened, and transferred in 250 mL Erlenmeyer flasks, sterilized at 15 psi for 30 min. Fresh culture of S. rolfsii was inoculated in sand maize meal medium and upheld at 28 ± 2 °C for 10 days. The inoculum of S. rolfsii was added to 20 g kg−1 soil near the stem zone and covered the inoculated area with leaf debris. Pots were regularly watered to keep a suitable moisture regime. Pots without inoculum served as a control. The appearance of disease symptoms on the stems of seedlings and their mortality were recorded periodically. Infected seedling stems were taken to re-isolate the pathogen on PDA media and compared with original isolates of S. rolfsii to prove Koch’s postulate theory.
2.3. Collection and Maintenance of Bio-Agents
The cultures of Trichoderma viride, Trichoderma harzianum, Pseudomonas fluorescens, and Bacillus subtilis, available in the advanced bio-control laboratory, Division of Plant Pathology, College of Agriculture, Bikaner, India, were used in the present study. Trichoderma spp. was maintained on 2% (w/v) PDA, while Bacillus subtilis and Pseudomonas fluorescens were maintained on nutrient agar (NA) media. All the freshly grown bio-agents were incubated in biological oxygen demand (BOD) at 28 ± 1 °C temperature for use in a further study.
2.4. In Vitro Antagonistic Assay
The dual culture method was followed to ascertain the antagonistic activity of T. viride and T. harzianum. Mycelial discs (5 mm diameter) of the pathogen and each bio-agent were kept on the surface of Petri plates containing potato dextrose agar media at 5 cm apart from the center. Control was maintained only with the mycelial disc of the pathogen in Petri dish. Petri dishes were incubated at 28 ± 2 °C for 7 days to grow the pathogen and bio-agents. The mycelial growth inhibition of fungus was calculated by using the formula suggested by Vincent [24]; Percent inhibition = Mycelial growth (mm) of S. rolfsii in control—Mycelial growth (mm) of S. rolfsii in the presence of fungal antagonist/Mycelial growth (mm) of S. rolfsii in control × 100.
The efficacy of bacterial antagonists P. fluorescens and B. subtilis on S. rolfsii was determined following the paper disc method [25]. P. fluorescens and B. subtilis were grown on Pseudomonas agar media and Nutrient agar media (PAF and NA) in test tube slants and incubated at 27 °C and 25 °C for 48 h, respectively. Ten millilitres of sterilized water was added into each bacterial bio-agent slant. The circular discs (5 mm in dia.) of the Whatman filter (No. 42) were cut and, after dipping in the suspension of respective bacterial antagonists, placed 1 cm inward from the periphery of Petri dishes containing potato dextrose agar media at four equal distances, having in the center the inoculum of the pathogen (S. rolfsii). The inoculated dishes were placed in an incubator at 28 ± 2 °C for 24 h and observations were recorded after incubation. The mycelial growth inhibition of S. rolfsii by respective bio-agents was estimated by using the following formula: Percent inhibition = Mycelial growth (mm) of S. rolfsii in control—Mycelial growth (mm) of S. rolfsii in the presence of bacterial antagonist/Mycelial growth (mm) of S. rolfsii in control × 100.
The effect of different culture filtrates of bio-agents, either alone or with combinations, was also tested on the pathogen [26]. Under culture filtrate test, experiments were comprised with nine treatments: T1—T. viride; T2—T. harzianum; T3—B. subtilis; T4—P. fluorescens; T5—T. viride + P. fluorescens; T6—T. harzianum + P. fluorescens; T7—T. viride + B. subtilis; T8—T. harzianum + B. subtilis; T9—Control (without culture filtrate). T. harzianum (Th-BKN) and T. viride (Tv-BKN) were grown in liquid Potato Dextrose Broth media (PDB), while Nutrient Broth (NB) was used for P. fluorescens (Pf-BKN) and B. subtilis (Bs-BKN). Bio-agents were incubated in BOD at 28 ± 2 °C for 7 days. The culture of T. harzianum (Th-BKN) and T. viride (Tv-BKN) was first filtered through double-layered cheese cloth, followed by filtering through (Whatman filter No. 1) filter paper. Then, the culture filtrate of the respective fungal antagonist was centrifuged at 10,000 rpm for 15 min at 4 °C. The centrifuged supernatant was again filtered through a 0.45 µm membrane filter to obtain conidia and fungal fragments free supernatant. The supernatant was stored in the refrigerator. Similarly, P. fluorescens (Pf-BKN) and B. subtilis (Bs-BKN) bacteria grown in NB media were then centrifuged at 10,000 rpm for 15 min at 4 °C and supernatant was passed through a bacteria-proof filter and stored in a refrigerator for further investigation. The respective supernatant of antagonists was dissolved in PDA medium at 1, 2.5, and 5% concentrations during pouring of the media in Petri dishes to ascertain inhibition potentiality. A mycelial disc (5 mm diameter) of S. rolfsii was placed in the center of Petri dishes. Each treatment was replicated thrice. Observation of the mycelial growth of the fungus was recorded after 7 days. Mycelial growth inhibition of fungus in each treatment was calculated according to [27]. Percent growth inhibition (PGI) = [Mycelial growth of S. rolfsii in control (mm)—Mycelial growth of S. rolfsii in the presence of supernatant (culture filtrate) (mm)/Mycelial growth of S. rolfsii in control (mm)] × 100.
2.5. Management of S. rolfsii by Bio-Agents under In Vivo Conditions
Pot experiments were conducted in control glasshouse conditions to ascertain the antagonistic activity of bio-agents against S. rolfsii; then, these bio-agents were further used in field experiments. The field experiments were conducted to manage the stem rot through seed and soil treatment by bio-agents during Kharif of 2017 and 2018 at an instructional research farm (situated at a latitude of 28°01′ N, longitude 73°22′ E and an elevation of 234.7 m above mean sea level). College of Agriculture, Swami Keshwanand Rajasthan Agricultural University, Bikaner falls in tropical climate conditions with an average annual rainfall of 260 mm that are favorable for the perpetuation and development of S. rolfsii.
All thirteen treatments, including control, were tested in three replications followed by Randomized Block Design [28] with plot size 3 × 4 m row-to-row spacing of 30 cm and plant-to-plant 10 cm at a fixed site (Table 1). HNG-10 susceptible variety was used in field trials and standard agronomic practices were followed. Talc-based formulations of four antagonists’, viz. T. harzianum (Th-BKN), T. viride (Tv-BKN), P. fluorescens (Pf-BKN), and B. subtilis (Bs-BKN), were used at 10 g kg−1 seed in individual bio-agent or combination of both bio-agents (5 + 5 g) for seed treatment. In contrast, these were used at 10 (5 + 5) kg ha−1 for soil application. Seeds were mixed separately with the respective doses of each bio-agent in a glass beaker for 10–20 min to ensure uniform coating. Farmyard manure (FYM) at 10 t ha−1 was equally applied in the field. Seeds were sown in the second week of June. The recommended dose of fertilizer (20 kg N and 40 kg P) was applied 35–40 days after sowing, while 250 kg Gypsum ha−1 was given at the peg formation stage. Five irrigations were given at the pegging, flowering, and pod development stage of the crop, and weeding and thinning of plants were done as and when required. Two drenchings of chlorpyriphos at 2.4 l ha−1 were applied for termite control.
Table 1.
Detail of bio-agents used under field conditions.
To maintain the optimum inoculum population, S. rolfsii was multiplied on a medium of sand maize (2:1). Flasks containing sterilized media were inoculated with S. rolfsii culture and incubated at 26 °C for 15 days. Sand maize meal inoculant of S. rolfsii was applied at 50 g per plot and mixed correctly on the top surface of the soil using a hand rack. Similarly, disease-infected plant debris was also spread in each plot to perpetuate and multiply the pathogen inoculum. Population dynamics of Trichoderma viride, T. harzianum, Pseudomonas fluorescence, Bacillus subtilis, and Sclerotium rolfsii were evaluated in rhizosphere soil by using the dilution plate count technique [29] (Hirte 1969). Rhizosphere soil samples were randomly taken from treated experimental groundnut field during 2017–2018. One gram soil was weighed and transferred to 10 mL of sterile distilled water, and then soil suspension was diluted from 101 to 108 after appropriately stirred. To estimate the population of S. rolfsii, Trichoderma viride, and T. harzianum, 1 mL of each soil suspension dilution was poured into the PDA-contained Petri plates with the help of a pipette. Tree replications of each dilution were kept. All the Petri plates were wrapped by parafilm and incubated at 28 ± 2 °C in BOD. The colony forming unit (CFU) of Trichoderma viride, T. harzianum, and S. rolfsii were observed in Petri plates after 3 days. The same technique was used for the estimation of the population of Pseudomonas fluorescens and Bacillus subtilis, but Nutrient agar media was used for the growth of bacteria using a dilution plate technique of rhizospheric soil at the dilutions of 101 to 106 and the colony was observed after 24 h in Petri plates.
Observation of disease incidence was recorded at the fortnightly interval after sowing. Disease incidence (DI) and Percent disease control (PDC) were calculated by using the following formulae: Disease incidence (DI) = [Number of infected plants/Total number of plants] × 100; Percent disease control (PDC) = [PDI in control − PDI in treatment/PDI in control] × 100; For the recording of dry weight, the groundnut plants were uprooted after 105 days of sowing, gently washed in tap water, and dried in the oven at 60 °C for 24 h. Five plants’ dry weight (DW) from each replication was recorded. Dry wt. in (%) was calculated using the following formula: Dry wt. in (%) = [Dry wt. in treatment − Dry wt. in control/Dry wt. of plants in control] × 100. Pod yield was calculated after harvesting groundnut. In observation of the weight of fresh pod yield, groundnut plants were pooled replication-wise individually after being harvested and dried, and then treatment-wise, mean weights of pod yield were calculated.
2.6. Statistical Analysis
Data on disease incidence in all the experiments were transformed into angular values before statistical analysis. Significant differences (p < 0.05) between the treatments were determined by Duncan’s multiple range test (DMRT). All analyses were done by using IBM SPSS v 16, Chicago, IL, USA).
3. Results
3.1. Isolation, Identification, and Pathogenicity of Sclerotium rolfsii
Results revealed that infected stem pieces and sclerotia produced mycelium on PDA media. Initially, the mycelial growth was white; later, it produced immature whitish sclerotia, which became mature and changed from brown to dark brown (Figure 3). On maturity, sclerotium was very hard and old sclerotia showed a shiny appearance. The identification of fungus and Koch’s postulate was confirmed as described in the materials and methods section.
Figure 3.
Validation of Koch’s postulate in groundnut plant.
3.2. Antagonistic Activity of Bio-Agents against S. rolfsii under In Vitro Conditions
In the dual culture method, results revealed that maximum growth inhibition of the pathogen was achieved with T. harzianum (Th-BKN) (83.12%), followed by T. viride (Tv-BKN) (73.16%). Similarly, in the paper disc method, the results revealed that the P. fluorescens (Pf-BKN) was found to be relatively a greater inhibiter and gave maximum (41.55%) mycelial growth inhibition of S. rolfsii, followed by B. subtilis (Bs-BKN) (28.57%) after incubation.
The efficacy of different BCA culture filtrates, either alone or in combination, was also tested on the mycelial growth of S. rolfsii to ascertain their antagonistic activities. Nine treatments, including the control, were executed in 1, 2.5, and 5% concentrations on a PDA medium. Results from Table 2 revealed that the culture filtrate of the respective bio-agents reduced the mycelial growth of pathogens to various extents. Maximum mycelial percent growth inhibition was recorded with T. harzianum and P. fluorescens (79.61, 83.51, and 86.77%), followed by the treatment T. viride and P. fluorescens (75.74, 79.63, and 83.14%), while B. subtilis (Bs-BKN) (60.92, 65.36, and 69.92%) was found to be less inhibitory compared to the rest of the bio-agents. The media-amended culture filtrates of the combined bio-agents at 5% were found to be superior in reducing the growth of pathogens compared to culture filtrates of a single bio-agent.
Table 2.
Effect of bioagents on Sclerotium rolfsii.
3.3. Management of S. rolfsii by Bio-Agents under In Vivo Conditions
Within the pot experiments, bio-agents effectively suppressed the mycelial growth of the test pathogen. These potential bio-agents were also tested under field conditions. Results revealed that stem rot was effectively suppressed by seed treatment (ST) and soil application (SA) of the BCAs. The lowest disease incidence and highest disease control of stem rot (7.40 and 69.37%) were recorded in treatment T10—consisting of T. harzianum and P. fluorescens, followed by T9—consisting of T. viride and P. fluorescens (8.00 and 66.88%). In contrast, the highest disease and lowest disease control were observed (18.28 and 24.34%) in T3—consisting of the B. subtilis treatment (Figure 4). The highest DW and highest percent increase in DW was observed in T10—consisting of T. harzianum and P. fluorescens (151 g plant−1 and 75.58%), followed by T9—consisting of the T. viride and P. fluorescens (147 g plant−1 and 70.93%) treatment, whereas the lowest DW and lowest percent increase in DW was recorded in T3—consisting of B. subtilis (102 g plant−1 and 18.60%) over the control. However, all the bio-agent treatments positively influenced the DW of the plants (Figure 5). The highest pod yield (2665 and 2498 kg ha−1) and highest percent increase in pod yield (96.38 and 84.08%) were recorded in T10—consisting of T. harzianum and P. fluorescens and T9—consisting of T. viride and P. fluorescens, whereas the lowest pod yield and lowest percent increase in pod yield (1877 kg ha−1 and 38.32%) were recorded in T3—consisting of the B. subtilis treatment. All other BCA treatments also positively influenced pod yield compared to the control (Figure 6).
Figure 4.
Effect of bio-agents on stem rot disease under field conditions; ST—Seed treatment; SA—Soil application.
Figure 5.
Effect of bio-agents on groundnut plants under field conditions; ST—Seed treatment; SA—Soil application.
Figure 6.
Effect of bio-agents on groundnut production under field conditions; ST—Seed treatment; SA—Soil application.
3.4. Inoculum Density of Microbial and Pathogen in Different Treatments
Results revealed that the average population of the BCA (T. viride, T. harzianum, P. fluorescence, and B. subtilis) increased up to 90 DAT in all treatments; thereafter, the populations of all BCAs were decreased. The average population of T. viride, T. harzianum, P. fluorescens, and B. subtilis was recorded from zero DAT to 120 DAT from rhizosphere soil during 2017–2018. The average population of T. viride was recorded in the range of 1.0 × 104 to 11.33 × 104 cfu/g, while the average population of T. harzianum was observed in the range of 1.67 × 104 to 15.67 × 104 cfu/g. Similarly, the average population of P. fluorescens was recorded in the range of 1.33 × 104 to 17.33 × 104 cfu/g, while the average population of B. subtilis was observed in the range of 0.33 × 104 to 8.33 × 104 cfu/g. Maximum average cfu/g soil for T. harzianum and P. fluorescens (15.67 × 104 and 17.33 × 104 cfu/g) was recorded at 90 DAT, followed by 9.00 × 104 and 9.33 × 104 cfu/g at 60 DAT, 7.67 × 104 and 9.00 × 104 cfu/g at 30 DAT, and 3.33 × 104 and 4.67 × 104 cfu/g at zero DAT in treatment, consisting of seed treatment and soil application with T. harzianum and Pf at 10 (5 + 5) g kg−1 + 10 (5 + 5) kg ha−1 compared to the control (1.33 × 104 and 1.67 × 104 cfu/g) during the year of 2017–2018. Similarly, the maximum average populations of T. viride and B. subtilis (8.33 × 104 and 7.67 × 104 cfu/g) was recorded at 90 DAT, followed by 7.00 × 104 and 7.33 × 104 cfu/g at 60 DAT, 5.67 × 104 and 5.00 × 104 cfu/g at 30 DAT, and 1.67 × 104 and 1.33 × 104 cfu/g at zero DAT in treatment, consisting of seed treatment and soil application with T. viride and Bs at 10 (5 + 5) g kg−1 + 10 (5 + 5) kg ha−1 compared to the control (1.00 × 104 and 0.33 × 104 cfu/g). The lowest average population of T. viride, T. harzianum, P. fluorescens, and B. subtilis (6.0 × 104, 7.00 × 104, 7.67 × 104, and 5.0 × 104 cfu/g) was also observed at 120 DAT, respectively. The lowest average population of S. rolfsii (8.23 × 104 cfu/g) was observed in treatment consisting of seed treatment and soil application with T. harzianum and Pf at 10 (5 + 5) g kg−1 + 10 (5 + 5) kg ha−1, followed by 8.85 × 104 cfu/g in treatment consisting of seed treatment and soil application with T. viride and Pf at 10 (5 + 5) g kg−1 + 10 (5 + 5) kg ha−1, respectively. While the highest average population (15.09 × 104 cfu/g) was recorded in treatment consisting of seed treatment with B. subtilis at 10 g kg−1 (Figure 7).
Figure 7.
Rhizosphere average population of Trichoderma viride, T. harzianum, Pseudomonas fluorescens, Bacillus subtilis, and Sclerotium rolfsii in different treatments during 2017–2018.
4. Discussion
4.1. Antagonistic Activity of Bio-Agents against S. rolfsii under In Vitro Conditions
Due to the soil-borne nature of Sclerotium rolfsii, the application of chemicals is hardly successful in the presence of a high level of inoculum in the soil and favorable climatic factors. Therefore, a cost-effective and eco-friendly approach would be the use of a biological control. The present study focused on the management of S. rolfsii with possible fungal and bacterial bio-agents. The antagonistic potential of BCAs against S. rolfsii was determined using the dual culture, paper disc, and culture filtrate methods. All bioagents efficiently inhibited the growth of S. rolfsii. During the study, we assessed the potentiality of fungal and bacterial bio-agents, both singly and in combinations, and it was observed that the combined formulation of T. harzianum and P. fluorescens suppressed the maximum percent growth inhibition of the S. rolfsii pathogen, followed by T. viride and P. fluorescens. Both BCAs developed faster than S. rolfsii, indicating that pathogenic fungi and antagonists competed for space and nutrients. It can be speculated that the activity of different hydrolytic enzymes released by the bio-agents caused this inhibition zone, which revealed that T. harzianum was superior in controlling the test pathogen compared to T. viride. The synthesis of hydrolytic enzymes (cellulases, chitinases, glucanases, and proteases) and secondary metabolites against S. rolfsii was observed by Sharma (2011) and Nicolas (2014) [30,31]. Prajapati et al. 2015 [32] reported that T. harzianum and T. viride completely inhibited mycelial development and sclerotia generation in S. rolfsii after 4–8 days of incubation. Similarly, Shivakumar et al. 2020 [33] observed that among the 10 isolates of T. viride and P. fluorescens, the isolates Tv3 and Pf5 effectively inhibited the mycelial growth and sclerotia of S. rolfsii under in vitro conditions. According to Subhendu Josh and Pan (2004) [34], a 2% concentration of the T. harzianum culture filtrate hindered the maximal mycelial growth of R. solani. These findings are also consistent with our studies.
P. fluorescens (Pf-BKN) was determined to be the most efficient bacterial bio-agent in terms of mycelial growth suppression, followed by B. subtilis. Both bacterial bio-agents considerably inhibited mycelial growth and were deemed superior. Babu and Kumar 2008, Rakh et al. 2011, and Darvin and Prasanna 2013 [35,36,37] observed that T. harzianum was more efficient against the mycelial growth of S. rolfsii than T. viride, Pseudomonas fluorescens, and B. subtilis. Suneeta et al. 2016 [38] reported that 26 Bacillus spp. isolates were tested in vitro against the collar rot pathogen. Five Bacillus spp. strains demonstrated the highest antagonistic activity against S. rolfsii. Similarly, Rajendra Prasad et al. 2017 [39] tested the efficiency of 24 fungal biocontrol agents and 12 bacterial biocontrol agents against the phytopathogenic fungus Sclerotium rolfsii using a dual culture approach. The BCAs T. harzianum-1 and P. f-3 were shown to be the most effective at inhibiting mycelium against Sclerotium rolfsii in vitro (95.1 and 60.80%), respectively. These findings are also consistent with our results. The BCAS T. harzianum and T. viride were shown to be significantly effective due to their ability to colonize the hyphae, disrupt the mycelial growth by producing volatile metabolites, and kill the pathogen [40,41]. Similarly, P. fluorescens was also found effective due to their excellent root colonizing ability and production of antifungal metabolites like pyoluteorin, 2,4- diacetyl phloroglucinol (DAPG), pyrrolnitrin, and phenazines against the hyphae of S. rolfsii [42,43], but it may be a possibility that B. subtilis was less inhibiting due to competition for food with other microbials. However, lower concentrations had a lower inhibitory effect on S. rolfsii growth. The 5% culture filtrate of the bioagents was shown to be more effective and superior than the 1.0% and 2.5% concentrations. During the investigation, we also observed that the mixed culture filtrate of the BCA was more efficient against test pathogens than separate BCA culture filtrates. Darvin et al. 2013 [37] revealed that the T. viride culture filtrate (Tv L) was found to be the most effective, inhibiting S. rolfsii to the greatest extent, followed by T. harzianum 14 (Th14) and T. harzianum (Th4). Similarly, Mishra et al. 2011 [44] found that the culture filtrate of T. viride (Tr 8) was effective against M. phaseolina and other soil-borne pathogens, which supports our results.
4.2. Management of S. rolfsii by Bio-Agents under Field Conditions
Groundnut stem rot is a major disease in most groundnut growing areas and often causes considerable pod yield losses if the crop is cultivated continuously in the same field for over two to three seasons. Due to the soil-borne nature of S. rolfsii and favored climatic conditions, it spreads very fast on the host crop. So, the antagonistic activities of bio-agents evaluated under in vitro and pots conditions were also tested under field conditions. Talc-based bio-agent formulations of T. harzianum and P. fluorescens and T. viride and P. fluorescens used in seed and soil treatment significantly reduced disease incidence. The BCAs T. harzianum and P. fluorescens and T. viride and P. fluorescens reduced the disease and increased plant growth. In addition, we observed that dual formulations of BCAs were more effective against S. rolfsii than individual BCAs. Manjula et al. 2004 [45] found that combining seed treatment with P. fluorescens (Pf1) (seed soaked in cell solution 109 CFU ml−1 for 5 min) with coated seed treatment with T. viride (2 g kg−1) greatly reduced the occurrence of stem rot. The maximum average cfu/g soil for T. harzianum and P. fluorescens (15.67 × 104 and 17.33 × 104 cfu/g) was recorded in combined talc-based formulations which reduced the population density of S. rolfsii. The population dynamic of bioagents at zero days was very low but later on it increased rapidly and peaked at 90 days. This finding is corroborated by studies conducted by [46,47]. Doley et al. 2017 [48] reported that the incidence of stem rot was found to be 45.83% in the combined application of mycorrhiza and Trichoderma (Gf+Sr+Tv) in the presence of the pathogen, as compared to 54.17% in the single application of mycorrhiza (Gf+Sr), 59.72% Trichoderma (C+Sr+Tv), and 68.06% in control ones (C+S. rolfsii). Similarly, Meena et al. 2018 [49] found that single and combined bio-agent treatments effectively control S. rolfsii. We observed that the application of farm yard manure (FYM) in experimental plots increased the multiplication and potentiality of bio-agents because FYM retains moisture, maintains the EC and pH, increases aeration in soil, and provides carbon and congenial environmental conditions to bio-agents and other beneficial microorganisms. Moreover, a BCA that may persist in the rhizosphere for years could be an important advantage over applying chemical pesticides. Jadon et al. 2018 [50] reported that the lowest percent stem rot was recorded in the soil application of Trichoderma isolate T- 170 enriched in FYM at 1 ton ha (50 kg per 200 kg FYM) and seed treatment of Pseudomonas fluorescens at 10 mL kg seed (TNAU) and seed treatment of Pseudomonas fluorescens at 10 mL kg seed (DGR) (T13). Similarly, Safari Motlagh et al. 2022 [14] observed that T. viride, A. flavus, and P. rubens were 44%, 42%, and 38% effective in alleviating the disease incidence and severity and positively increased the height, fresh weight, and dry weight of the groundnut plants, which also corroborates our study.
The dry weight and pod yield of plants were also substantially increased and considerably higher in the combined treatment of T. harzianum and P. fluorescens, followed by T. viride and P. fluorescens. Similarly, the highest increased DW was observed with the same BCA treatments. The BCA P. fluorescens, individually or with a combination of other bio-agents, also enhanced the growth of plants due to PGPR activities. This treatment module considerably reduced groundnut seedling mortality compared to the untreated control. In a similar line of research, Rakholiya and Jadeja 2010 [51] evaluated various bio-agents with seed treatment for the management of stem rot of groundnut under field conditions and found significantly less disease incidence and high yield with seed treatment of T. harzianum (10 g kg−1). Similarly, Rasu et al. 2013 [52] reported that the combined soil application of farmyard manure-based bio-formulation of P. fluorescens (Pf1) (2.5 g/pot) and T. asperellum (Th1) (2.5 g/pot) resulted in significantly less incidence of root rot of sugar beet caused by S. rolfsii. Sarita et al. 2018 [53] also reported the effectiveness of T. harzianum and FYM, which gave a maximum reduction of stem rot, followed by T. harzianum, which agrees with our study. Seed treated with T. harzianium (4 g kg−1 seed) and carboxin (0.5 g kg−1 seed) provided maximum protection to the chickpea crop by giving maximum seedling emergence (495.0/20 m2), final plant stand (480/20 m2), and grain yield (l8.2 q ha−1), according to Kumar et al. 2008 [54]. Rajendra Prasad et al. 2017 [39] tested Pseudomonas fluorescence and Trichoderma harzianum in several treatment combinations against tomato S. rolfsii. They found that seed treatment with Pseudomonas fluorescence-3 and soil application with Trichoderma harzianum-1, followed by seed treatment with Trichoderma harzianum-1 and soil application with Pseudomonas fluorescence-3, resulted in 52.08 and 49.17% germination when inoculated with S. rolfsii, respectively, which supports our findings.
5. Conclusions
In the present study, the research results performed under in vitro and in vivo conditions revealed that the groundnut stem rot disease can significantly be controlled by the BCAs T. viride, T. harzianum, P. fluorescens, and Bacillus subtilis. Based on our results, it is concluded that the dual formulation of T. harzianum and P. fluorescens, followed by T. viride and P. fluorescens, were the most effective BCAs in suppressing the S. rolfsii and enhancing the dry weight and pod yield under in vitro and in vivo conditions. Therefore, an integrated disease management module with these BCAs needs to be developed and validated with a farmers’ participatory mode under field conditions.
Author Contributions
Conceptualization and design: P.N.M. and A.K.M.; interpretation of data and original draft preparation: P.N.M. and A.K.M.; analysis and interpretation of data and writing: R.K.T., M.K.L. and R.K.; performed analysis, interpretation of data and resources, revised draft manuscript and supervision, R.K., M.K.L. and R.K.T. All authors have read and agreed to the published version of the manuscript.
Funding
This research received no external funding.
Institutional Review Board Statement
Not Applicable.
Informed Consent Statement
Not Applicable.
Data Availability Statement
The datasets generated during and/or analyzed during the current study are available from the corresponding author on reasonable request.
Acknowledgments
The authors are grateful to the Head, Department of Plant Pathology, College of Agriculture, SKARU, Bikaner and Director, ICAR—Central Research Institute for Jute and Allied Fibres, Barrackpore, Kolkata 700120, India for their support to undertake the investigation.
Conflicts of Interest
The authors declare that they have no known competing financial interests that could have appeared to influence the work reported in this paper.
References
- Wiess, E.A. Oilseed Crops; Longman Group Ltd.: London, UK, 1983. [Google Scholar]
- Directorate of Economics and Statistics, Department of Agriculture Cooperation and Farmers Welfare, Ministry of Agriculture and Farmers Welfare, Government of India. Directorate of Economics and Statistics, Department of Agriculture and Cooperation of India. 2017. Available online: https://desagri.gov.in/ (accessed on 25 May 2024).
- Priya, R.S.; Chinnusamy, C.; Manicaksundaram, P.; Babu, C. A review on weed management in groundnut (Arachis hypogaea L.). Int. J. Agric. Sci. Res. 2013, 3, 163–172. [Google Scholar]
- Kumar, R.; Mishra, P.; Singh, G.; Prasad, C.S. Effect of media, temperature and pH on growth and sclerotial production of Sclerotium rolfsii. Ann. Plant Prot. Sci. 2008, 16, 531–532. [Google Scholar]
- Akgul, D.S.; Ozgonen, H.; Erkılıc, A. The effects of seed treatments with fungicides on stem rot caused by Sclerotium rolfsii Sacc., in peanut. Pak. J. Bot. 2011, 43, 2991–2996. [Google Scholar]
- Yan, L.Y.; Song, W.D.; Lei, Y.; Wan, L.Y.; Huai, D.X.; Kang, Y.P.; Chen, Y.P.; Liao, B.S. Evaluation of peanut accessions for resistance to Sclerotium stem rot. Chin. J. Oil Crop Sci. 2019, 41, 781–787. [Google Scholar]
- Mayee, C.D.; Datar, V.V. Diseases of Groundnut in the Tropics. Trop. Plant Pathol. 1988, 5, 85–118. [Google Scholar]
- Sharma, P.; Saini, M.K.; Deep, S.; Kumar, V. Biological controls of groundnut root rot in farmer fields. J. Agric. Sci. 2012, 4, 1916–1925. [Google Scholar]
- Panth, M.; Hassler, S.C.; Baysal-Gurel, F. Methods for management of soil borne diseases in crop production. Agriculture 2020, 10, 16. [Google Scholar] [CrossRef]
- Christopher, D.J.; Raj, T.S.; Rani, S.U.; Udhayakumar, R. Role of defense enzymes activity in tomato as induced by Trichoderma virens against Fusarium wilt caused by Fusarium oxysporum f sp. lycopersici. J. Biopestic. 2010, 3, 158–162. [Google Scholar]
- Verma, P.P.; Shelake, R.M.; Das, S.; Sharma, P.; Kim, J.Y. Plant growth-promoting rhizobacteria (PGPR) and fungi (PGPF): Potential biological control agents of diseases and pests. In Microbial Interventions in Agriculture and Environment; Springer: Singapore, 2019; pp. 281–311. [Google Scholar]
- Elad, Y.; Chet, I.; Boyle, P.; Henis, Y. Parasitism of Trichoderma spp., Rhizoctonia solani and Sclerotium rolfsii scanning electron microscopy fluorescent microscopy. J. Phytopathol. 1983, 73, 85–88. [Google Scholar] [CrossRef]
- Rekha, D.; Patil, M.B.; Shetty, P.S.; Swamy, K.M.; Rajini, B.G. In vitro screening of native Trichoderma isolates against Sclerotium rolfsii causing collar rot of ground nut. Int. J. Sci. Nat. 2012, 3, 117–120. [Google Scholar]
- Motlagh, M.R.S.; Farokhzad, M.; Kaviani, B.; Kulus, D. Endophytic fungi as potential biocontrol agents against Sclerotium rolfsii Sacc.—The causal agent of peanut white stem rot disease. Cells 2022, 11, 2643. [Google Scholar] [CrossRef] [PubMed]
- Sultana, F.; Hossain, M.M. Assessing the potentials of bacterial antagonists for plant growth promotion, nutrient acquisition, and biological control of Southern blight disease in tomato. PLoS ONE 2022, 17, e0267253. [Google Scholar] [CrossRef] [PubMed]
- Bailey, K.L.; Boyetchko, S.M.; Längle, T. Social and economic drivers shaping the future of biological control: A Canadian perspective on the factors affecting the development and use of microbial biopesticides. Biol. Control 2010, 52, 221–229. [Google Scholar] [CrossRef]
- Khachatourians, G.G. Insecticides, microbial. In Moselio Schaechter, Encyclopedia of Microbiology, 3rd ed.; Academic Press: Cambridge, MA, USA, 2009; pp. 95–109. ISBN 9780123739445. [Google Scholar] [CrossRef]
- Mathivanan, N.; Srinivasan, K.; Chelliah, S. Field evaluation of Trichoderma viride Pers. ex. S. F. Gray and Pseudomonas fluore-scens Migula against foliar diseases of groundnut and sunflower. J. Biol. Control 2000, 14, 31–34. [Google Scholar]
- Moradi, H.; Bahramnejad, B.; Amini, J.; Siosemardeh, A.; Allahverdipoor, K. Suppression of chickpea (Cicer arietinum L.) Fusarium wilt by Bacillus subtillis and Trichoderma harzianum. Plant Omics 2012, 5, 68–74. [Google Scholar]
- Rangaswami, G.; Mahadevan, A. An agar blocks technique for isolating soil micro-organisms with special reference to pythiaceous fungi. Sci. Cult. 1999, 24, 85. [Google Scholar]
- Barnett, H.L.; Hunter, B.B. Illustrated Genera of Imperfect Fungi, 4th ed.; APS Press: Saint Paul, MN, USA, 1998; p. 218. [Google Scholar]
- Meena, P.N.; Meena, A.K.; Ram, C. Morphological and molecular diversity in Sclerotium rolfsii Sacc., infecting groundnut (Arachis hypogaea L.). Discov. Agric. 2023, 1, 3. [Google Scholar] [CrossRef]
- Shokes, F.M.; Rozalski, K.; Gorbet, D.W.; Brenneman, T.B.; Berger, D.A. Techniques for inoculation of peanut with Sclerotium rolfsii in the greenhouse and field. Peanut Sci. 1996, 23, 124–128. [Google Scholar] [CrossRef]
- Vincent, J.M. Distortion of Fungal Hyphæ in the Presence of Certain Inhibitors. Nature 1947, 159, 850. [Google Scholar] [CrossRef]
- Loo, Y.L.; Skell, P.S.; Thornberry, H.H.; Ehrlich, J.; McGuire, J.M.; Savage, G.M.; Sylvester, C. Assay of streptomycin by the paper disc plate method. J. Bacteriol. 1945, 50, 701–709. [Google Scholar] [CrossRef]
- Upadhyay, R.S.; Rai, B. Studies on antagonism between F. udum Butler and root region micro flora of pigeonpea. Plant Soil 1987, 101, 79–93. [Google Scholar] [CrossRef]
- Dennis, C.; Webster, J. Antagonistic properties of species groups of Trichoderma III, hyphae interaction. Trans. Br. Mycol. Soc. 1971, 57, 363–369. [Google Scholar] [CrossRef]
- Cochran, W.G.; Cox, G.M. Experimental Designs, 2nd ed.; John Wiley & Sons, Inc.: New York, NY, USA, 1957. [Google Scholar]
- Hirte, W.F. The use of dilution plate method for the determination of soil microflora. The qualitative demonstration of bacteria and actinomycetes. Zentralblatt Bakteriol. Parasitenkd. Infekt. Hyg. 1969, 123, 167–178. [Google Scholar]
- Sharma, P.; Kumar, V.; Ramesh, R.; Saravanan, K.; Deep, S.; Sharma, M.; Mahesh, S.; Dinesh, S. Biocontrol genes from Trichoderma species: A review. Afr. J. Biotechnol. 2011, 10, 19898–19907. [Google Scholar]
- Nicolas, C.; Hermosa, R.; Rubio, B.; Mukherjee, P.K.; Monte, E. Trichoderma genes in plants for stress tolerance-status and prospects. Plant Sci. 2014, 228, 71–78. [Google Scholar] [CrossRef] [PubMed]
- Prajapati, B.K.; Patel, J.K.; Patil, R.K. Bioefficacy of Trichoderma spp. against Sclerotium rolfsii Sacc. an incitant of collar rot of chick pea in vitro. Bioscan 2015, 10, 1745–1748. [Google Scholar]
- Sivakumar, T.; Renganathan, P.; Sanjeevkumar, K.; Sudhasha, S. Bio efficiency of certain bio control against for the management of stem rot of groundnut (Arachis hypogaea L.) caused by Sclerotium rolfsii (sacc.). Plant Arch. 2020, 20, 1291–1297. [Google Scholar]
- Subhendu, J.; Pan, S. Stable mutants of Trichoderma virens for biological control of R. solani that causes seedling blight in greengram. Indian J. Agric. Sci. 2004, 34, 476–479. [Google Scholar]
- Babu, V.K.; Kumar, M.R. Mycoparastic activity of Trichoderma harzianum against stem rot pathogen (Sclerotium rolfsii) of groundnut. Int. J. Life Sci. Biotechnol. Pharma Res. 2008, 38, 593–595. [Google Scholar]
- Rakh, R.R.; Raut, L.S.; Dalvi, S.M.; Manwar, A.V. Biological control of Sclerotium rolfsii causing stem rot of groundnut by Pseudomonas cf monteilii. Recent Res. Sci. Technol. 2011, 3, 26–34. [Google Scholar]
- Darvin, G.; Prasanna, V.K. Effect of bio-control agents on radial growth of Sclerotium rolfsii in vitro. Int. J. Appl. Biol. Pharm. Technol. 2013, 4, 61–64. [Google Scholar]
- Suneeta, P.; Aiyanathan, K.; Nakkeeran, S. Efficacy of Bacillus spp. in the management of collar rot of gerbera under protected cultivation. Res. Crops 2016, 17, 745–752. [Google Scholar] [CrossRef]
- Rajendraprasad, M.; Sagar, B.V.; Uma, D.G.; Koteswar, R.S.R. Biological control of tomato damping off caused by Sclerotium rolfsii. J. Entomol. Zool. Stud. 2017, 5, 113–119. [Google Scholar]
- Shaigan, S.; Seraji, A.; Moghaddam, S.A. Identification and investigation on antagonistic effect of Trichoderma spp. on tea seedlings white foot and root rot (Sclerotium rolffsi Sacc) in vitro condition. Pak. J. Biol. Sci. 2008, 11, 2346–2350. [Google Scholar] [CrossRef] [PubMed]
- Mukhopadhyay, A.N. Challenges, changes and choices before Trichoderma based biopesticides. In Proceedings of the 5th International Conference on Biopesticides Stakeholders, Perspectives, New Delhi, India, 7 April 2009. [Google Scholar]
- Chin-A-Woeng, T.F.C.; Thomas-Oates, J.E.; Lugtenberg, B.J.J.; Bloemberg, G.V. Introduction of the phzH gene of Pseudomonas chlororaphis PCL1391 extends the range of biocontrol ability of phenazine-1-carboxylic acid producing Pseudomonas spp. strains. Mol. Plant-Microbe Interact. 2001, 14, 1006–1015. [Google Scholar] [CrossRef] [PubMed]
- Raaijmakers, J.M.; Vlami, M.; De Souza, J.T. Antibiotic production by bacterial biocontrol agents. Antonie Van Leeuwenhoek 2002, 81, 537–547. [Google Scholar] [CrossRef] [PubMed]
- Mishra, B.K.; Mishra, R.K.; Mishra, R.C.; Tiwari, A.K.; Yadav, R.S.; Dikshit, A. Biocontrol efficacy of Trichoderma viride isolates against fungal plant pathogens causing disease in Vigna radiata L. Arch. Appl. Sci. Res. 2011, 3, 361–369. [Google Scholar]
- Manjula, K.; Kishore, G.K.; Girish, A.G.; Singh, S.D. Combined application of Pseudomonas fluorescens and Trichoderma viride has an improved biocontrol activity against stem rot in groundnut. Plant Pathol. J. 2004, 20, 75–80. [Google Scholar] [CrossRef]
- Dupler, M.; Baker, R. Survival of Pseudomonas putida, a biological control agent in soil. Phytopathology 1984, 74, 195–200. [Google Scholar] [CrossRef]
- Bora, P.; Bora, L.C.; Begum, M. Eco-friendly management of soil borne diseases in brinjal through application of antagonistic microbial population. J. Biol. Control 2013, 27, 29–34. [Google Scholar]
- Doley, K.; Dudhane, M.; Borde, M. Biocontrol of Sclerotium rolfsii in groundnut by using microbial inoculants. Not. Sci. Biol. 2017, 9, 124–130. [Google Scholar] [CrossRef][Green Version]
- Meena, M.C.; Meena, A.K.; Meena, P.N.; Meena, R.R. Management of stem rot of groundnut incited by S. rolfsii through important bio-agents. Chem. Sci. Rev. Lett. 2018, 7, 1012–1017. [Google Scholar]
- Jadon, K.S.; Thirumalaisamy, P.P.; Padavi, R.D.; Koradia, V.G. Biological control of Sclerotium rolfsii and Aspergillus flavus infection on peanut with combining Trichoderma harzianum and Pseudomonas fluorescens in the field. J. Plant Pathol. 2018, 48, 80–88. [Google Scholar]
- Rakholiya, K.B.; Jadeja, K.B. Effect of seed treatment of biocontrol agents and chemicals for management of stem and pod rot of groundnut. Int. J. Plant Prot. 2010, 3, 276–278. [Google Scholar]
- Rasu, T.; Sevugapperumal, N.; Thiruvengadam, R.; Ramasamy, S. Biological control of sugar beet root rot caused by Sclerotium rolfsii. Int. J. Biol. Ecol. Environ. Sci. 2013, 2, 7–10. [Google Scholar]
- Sarita, S.S.; Ratnoo, R.S. Bio-efficacy and management of stem rot (Sclerotium rolfsii) of groundnut with different fungicides and bio-agents. Int. J. Chem. Stud. 2018, 6, 492–495. [Google Scholar]
- Kumar, R.; Mishra, P.; Singh, G.; Yadav, R.S. Integration of bioagents and fungicides for management of collar rot of chickpea. J. Biol. Control 2008, 22, 487–489. [Google Scholar]
Disclaimer/Publisher’s Note: The statements, opinions and data contained in all publications are solely those of the individual author(s) and contributor(s) and not of MDPI and/or the editor(s). MDPI and/or the editor(s) disclaim responsibility for any injury to people or property resulting from any ideas, methods, instructions or products referred to in the content. |
© 2024 by the authors. Licensee MDPI, Basel, Switzerland. This article is an open access article distributed under the terms and conditions of the Creative Commons Attribution (CC BY) license (https://creativecommons.org/licenses/by/4.0/).